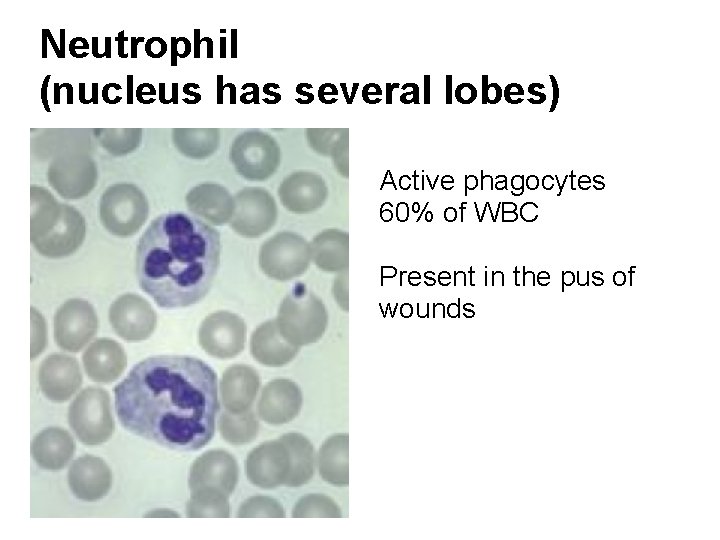
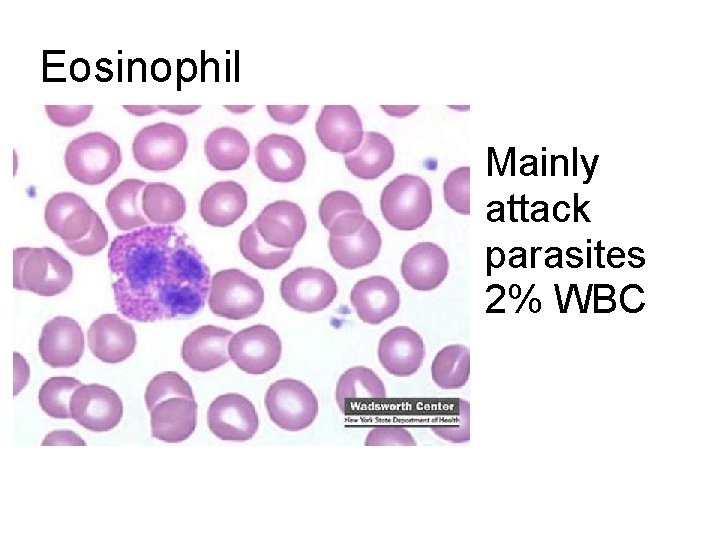
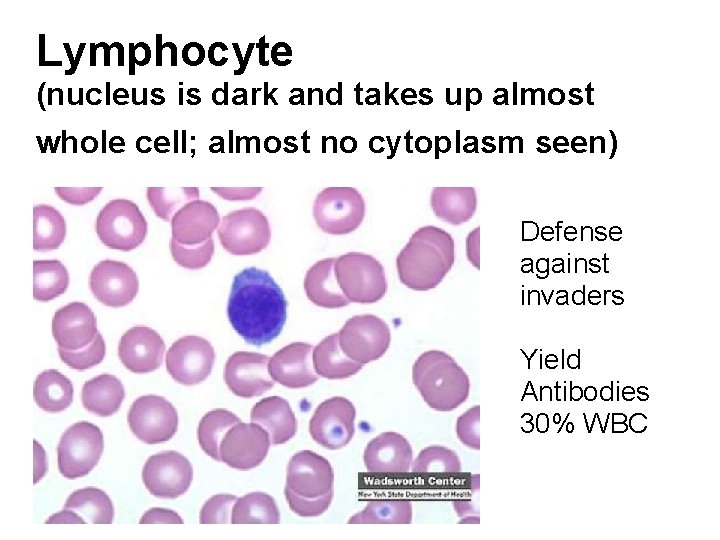

Cardiovascular System heart and blood vessels Systemic Circulation

Cardiovascular System heart and blood vessels

Systemic Circulation – delivers blood to all body cells and carries away waste Pulmonary Circulation – eliminates carbon dioxide and oxygenates blood (lung pathway)

Structure of the Heart Size – about 14 cm x 9 cm (the size of a fist). Located in the mediastinum (space between lungs, backbone, sternum), between the 2 nd rib and the 5 th intercostal space. The distal end of the heart is called the apex.

Fibrous Pericardium encloses the heart (like a bag) and has 2 layers • visceral pericardium (inner) • and parietal pericardium (outer, attached to diaphragm, sternum and vertebrae)

Pericardial cavity – contains fluid for the heart to float in, reducing friction Wall of the Heart Epicardium – outer layer, reduces friction Myocardium – middle layer, mostly cardiac muscle Endocardium – thin inner lining, within chambers of the heart

Heart Chambers & Valves • Your heart is a double pump. Circulation is a double circuit: Pulmonary (lungs only) and systemic (rest of the body) • Heart has 4 chambers:

• 2 Atria – thin upper chambers that receive blood returning to the heart through veins. . Right and Left Atrium • 2 Ventricles – thick, muscular lower chambers. Receive blood from the atria above them. Force (pump) blood out of the heart through arteries. Right and left ventricle. – Septum – separates the right and left sides of the heart

• Valves of the Heart – allow one-way flow of blood. 4 total • (2 Atrioventricular Valves (AV) & 2 Semilunar valves)

• Left Atrioventricular valve – also called the bicuspid valve or mitral valve. Between left atrium and ventricle • Right Atrioventricular valve – also called the tricuspid valve. Between right atrium and ventricle – Aortic Semilunar – or just aortic valve. Between the left ventricle and the aorta – Pulmonary Semilunar, or just pulmonary valve. Between the right ventricle and the pulmonary artery

Path of Blood Flow

Heart Actions • Cardiac Cycle: One complete heartbeat. The contraction of a heart chamber is called systole and the relaxation of a chamber is called diastole.

The cusps (flaps) of the bicuspid and tricuspid valves are anchored to the ventricle walls by fibrous “cords” called chordae tendineae, which attach to the wall by papillary muscles. This prevents the valves from being pushed up into the atria during ventricular systole.

ECG – electrocardiogram – a recording of the electrical events (changes) during a cardiac cycle (heartbeat). • P Wave – depolarization of the atria (atrial contraction – systole) • QRS Complex – depolarization of the ventricles (ventricular contraction, systole) • T Wave – Repolarization of the ventricles Heart Sounds – opening and closing of the valves, flow of blood into and out of the chambers, vibrations in muscle

Analyze an ECG Each one of the figures represents an ECG pattern displaying three types of abnormal rhythms: Tachycardia, Bradycardia, and Arrhymthmia. Identify each.

Cardiac Conduction S-A Node Junctional Fibers A-V Node A-V Bundle Perkinje Fibers

Regulation of Cardiac Cycle controlled by the cardiac center within the medulla oblongata. The cardiac center signals heart to increase or decrease its rate according to many factors that the brain constantly monitors. Muscle Activity Body Temperature Blood ion levels (potassium & calcium)

BLOOD Blood transports substances and maintains homeostasis in the body

Three Types of Blood Cells red blood cells (erythrocytes) white blood cells (leukocytes) platelets (thrombocytes) HEMATOPOEISIS – formation of blood cells (bone marrow) Liver & Spleen - phagocytosis

Elements Critical to RBC Production • Folic Acid • Vitamin B 12 • Iron • Too few RBC = anemia

Oxygen Levels Oxyhemoglobin = plenty of oxygen; bright red Deoxyhemoglobin = low in O 2, “bluish red”

WHITE BLOOD CELLS (Leukocytes) • General function is to protect the body against disease • There are several different kinds of WBCs Granulocytes (granular cytoplasm) Neutrophils, Eosinophils, Basophils Agranulocytes (lacking granular cytoplasm) Monocytes, Lymphocytes
Neutrophil (nucleus has several lobes) Active phagocytes 60% of WBC Present in the pus of wounds

Basophil Produces Heparin and Histamines Important in Inflammatory Reaction 1% WBC
Eosinophil Mainly attack parasites 2% WBC

Monocyte (larger cell, horseshoe shaped nucleus) Become macrophages
Lymphocyte (nucleus is dark and takes up almost whole cell; almost no cytoplasm seen) Defense against invaders Yield Antibodies 30% WBC

Platelets (thrombocytes) Blood clots and vessel repair

Plasma Proteins • Albumins – blood pressure • Globulins (alpha, beta, gamma) – transport lipids and antibodies for immunity • Fibrinogen – important for blood clotting Fibrogen • Fibrin

HEMOSTASIS The process of stopping bleeding Involves the coagulation and clotting of the blood to seal the site of damage

• THROMBUS – blood clot (abnormal) • EMBOLUS – when the clot moves to another place.

ANEMIA • Iron-Deficiency Anemia (most common) • Aplastic Anemia – bone marrow does not produce enough RBC • Hemorrhagic anemia – due to extreme blood loss • Pernicious anemia – B 12 deficiency • Sickle Cell Anemia (genetic)

Leukemia • Type of cancer • Overproduction of immature white blood cells • They take the place of RBCs • Treatable with bone marrow transplants, chemotherapy, radiation

Infectious mononucleosis sometimes called "mono" or "the kissing disease, " is an infection usually caused by the Epstein. Barr virus (EBV). EBV is very common, and many people have been exposed to the virus at some time in childhood.

Blood poisoning - Septicemia • An infection enters the blood stream • Can be deadly • Treated with antibiotics

Thrombocytopenia • Low production of Platelets • Causing bleeding or bruising

Jaundice • In newborns, caused by the liver not functioning fully • Secretes bilirubin into the blood causing the yellow color • Exposure to flourescent lights (bili lights) will break down the substance

SICKLE CELL ANEMIA • Genetic Disorder • Abnormally shaped blood cells • Parents can be carriers (asymptomatic)

Complications 1. Pain 2. Lethargy 3. Lifelong anemia (low red blood count) 4. Organ failure 5. Stroke

HEMOPHILIA This disorder causes a failure of the blood to clot Patients can be treated with blood transfusions that include clotting agents.

Blood Type is Controlled by 3 Alleles 4 Possible Blood Types Alleles: A, B, O A & B are codominant O is recessive

Genotypes

Rh Factor A person can either be Rh + or Rh – (positive is dominant)
- Slides: 42